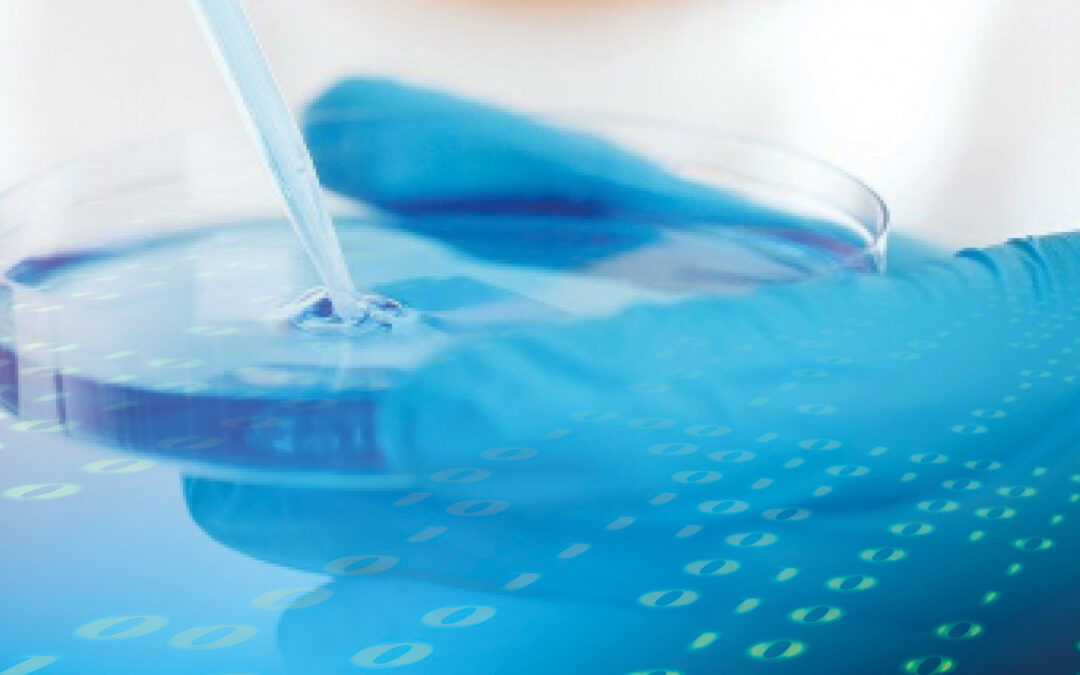

Finalizó la XXV Jornada de Investigación de los Posgrados de Alta Especialidad en Medicina
El viernes 2 de febrero del año en curso, se llevó a cabo la ceremonia de clausura del XXV aniversario de la Jornada de Investigación de Posgrados de Alta Especialidad de la Facultad de Medicina, UNAM.
Como parte del presídium, en el auditorio “Dr. Raoul Fournier Villada” estuvieron presentes la recién nombrada directora de la Facultad de Medicina, Dra. Ana Carolina Sepúlveda Vildósola, la Dra. Teresita Corona Vázquez, jefa de la División de Estudios de Posgrado de la Facultad de Medicina, el área encargada de organizar la Jornada, el Dr. Omar Pérez Enríquez, coordinador de PAEM de la DEP y el Dr. Oscar Arrieta Rodríguez, director general del Instituto Nacional de Cancerología, quien dio la conferencia magistral de la ceremonia “Importancia del desarrollo de la Investigación en cáncer”.
Durante el transcurso de la semana del 29 de enero al 2 de febrero que duró la Jornada, participaron médicas y médicos especialistas, un total de 1203 alumnos, entre quienes se contaron 549 mujeres y 654 hombres pertenecientes a 244 diferentes programas de posgrado de 84 sedes hospitalarias de la República Mexicana, avaladas por la Facultad de Medicina. Además, también participaron 541 profesores de alta especialidad como evaluadores. Asimismo, se realizaron 44 aulas virtuales y en total, se avaluaron a 300 alumnos al día.
Al término de la Jornada y durante la ceremonia de clausura, se les entregó una constancia especial a 10 alumnos destacados, en reconocimiento por la calidad de investigación de sus trabajos presentados en la Jornada. Entre ellos, Dra. Melisa Cañete Alavez, quien presentó el trabajo “Estudio descriptivo de las características clínicas en niñas y adolescentes con diagnóstico de TEA en el servicio de Pediatría del Desarrollo y la Conducta del Hospital Infantil de México Federico Gómez”, conmovió a los presentes con su discurso que resaltaba la importancia de la reivindicación de la tarea diaria de los médicos, no para la sociedad sino para sí mismos, el rescatar la emoción especial que les debe causar su crucial labor diaria de manera individual y en equipo.
Los otros nueve alumnos destacados fueron: Dr. Jorge Luis Barzallo Sánchez, del Hospital General de México “Dr. Eduardo Liceaga”; Dra. Diana Ari Mancera Rodríguez, del Centro Médico Nacional “20 de Noviembre”; Dra. Susana Gloria Quispe Ticona, del Hospital Regional de Alta Especialidad de la Península de Yucatán; Dr. Víctor Sánchez Blancas, de la Fundación Teletón México AC; Dra. María de Lourdes García Colmenero, del Hospital Ángeles del Pedregal; Dr. Erick Benjamín Trujillo Virgen, de la UMAE Hospital de Cardiología Centro Médico Nacional Siglo XXI; Dra. Brenda Angélica López Navarro, de la UMAE Hospital de Especialidades “Dr. Bernardo Sepúlveda” del Centro Médico Nacional Siglo XXI; Dr. Alejandro Bolaños Averame y Dra. Sandra Badial Ochoa, del Instituto Nacional de Neurología y Neurocirugía “Manuel Velasco Suárez”.

Primera jornada del morado al verde. Conversemos sobre el #8M
Recomendaciones para alumnos y profesores antes y durante la jornada de investigación
Recomendaciones para alumnos
Recomendaciones para profesores
Recomendaciones para la sesión por videoconferencia











